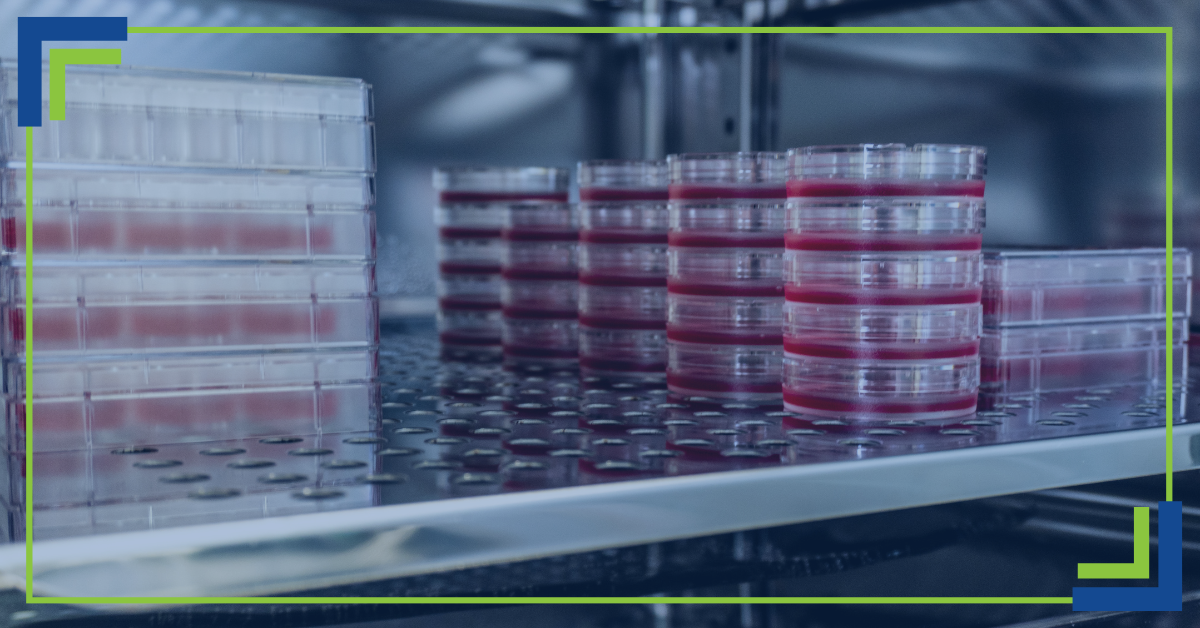

Precision and separation are essential parts of laboratory science. Without them, we wouldn’t have a large majority of the breakthroughs that have shaped our world. It’s no wonder, then, that one of the most important processes for achieving both of them is electrophoresis. It’s used to separate charged molecules such as DNA, RNA, and proteins based on electrical charge and size.
This process has become a fundamental pillar of research, helping scientists achieve accurate results. In this blog, we’ll take a look at what it is, how it works, and how it can be used.
What Is Electrophoresis
Essentially, this scientific process is a technique that separates molecules as they move through a medium (such as a capillary or gel) under an electric field’s influence. Depending on the size, shape, and charge, molecules will travel at different speeds, which allows them to be visually distinguished.
Think of a sieve. Smaller particles are able to easily pass through, while larger ones have a more difficult time doing so. In this instance, small molecules can travel with ease, creating a clear pattern of separation.
This useful process is essential in the identification, analysis, and purification of biological samples. This makes it a mainstay technique in genetics, molecular biology, and biochemistry.
How It Works
Here’s how the process is carried out:
Step 1: Preparing the Gel and Buffer
A gel matrix made of agarose or polyacrylamide is prepared. This gel will act as the filter. The buffer solution is used to conduct electricity and uphold a stable pH level, which is essential in obtaining accurate results.
Step 2: Loading the Samples
Prepared samples are then mixed with a loading dye to increase their visibility for observation. They’re pipetted into small wells on one end of the gel.
Step 3: Applying the Electric Current
Now that the setup is complete, the electric current is applied. Molecules such as DNA are negatively charged, so they will migrate towards positive electrodes. Smaller molecules will move through the gel more quickly. This step creates size-based separation.
Step 4: Visualizing the Results
Once complete, the gel is stained with a dye that binds to the molecules, making them visible. The bands are then observed under UV light, photographed, and analyzed.
Common Types
- Agarose Gel: A staple in molecular biology labs, this method is used in DNA and RNA fragment separation.
- SDS-PAGE (Polyacrylamide Gel Electrophoresis): This method is used to separate proteins based on size, denaturing them to ensure molecular weight analysis is accurate.
- Capillary: An automated method that foregoes gels in favor of narrow capillaries. Rapid, quantitative results are made possible, making this technique useful for chemistry and pharmaceutical labs.
- Isoelectric Focusing: This technique is useful in protein separation based on isoelectric point, which refers to the pH level at which a molecule carries no net charge. This is a useful method in quality assurance and protein characterization.
Why It’s Important for Laboratory Work
There are several useful applications for this process, so let’s discuss the common ones.
- Research Applications: Genetics, molecular biology, and proteomics rely heavily on electrophoresis. It’s used to verify PCR products, confirm protein purity, and analyze gene expression
- Medical and Clinical Diagnostics: In clinical settings, this method can be instrumental in diagnosing diseases. This is done by identifying specific proteins and patterns in DNA.
- Forensic Science and Environmental Testing: DNA fingerprinting wouldn’t be what it is today without gel electrophoresis. It’s essential in matching genetic material in criminal investigations, as well as identifying contaminants in water and environmental testing.
- Quality Control in Industry: Product purity and consistency is ensured in biotechnology and food production, making it vital in quality control processes. Without it, it would be much more difficult to detect contamination or determine the composition of food additives.
Looking for an even deeper dive? This page provides a wealth of information!
Advantages and Limitations
As with all laboratory techniques, gel electrophoresis has both advantages and drawbacks. Let’s lay them out.
Advantages
- Accuracy and reproducibility across various sample types
- Standardized procedure that’s easily integrated into laboratory workflows
- Cost-effectiveness
- Adaptable to different charges and molecular sizes
Limitations
- Not ideal for processing large numbers of samples due to its time-consuming nature
- Requires expertise in imaging, straining, and interpretation of results
- Certain techniques could damage or alter samples during the analysis phase
Its Future in Science
What does the future of this vital lab technique look like? The short version is simply “bright.” But taking a closer look, the possibilities are exciting to any researcher. Automation and microfluidic innovations are helping to increase speed and efficiency, while accuracy and data interpretation are getting big boosts thanks to digital imaging and AI-assisted analysis.
In addition, electrophoresis is being integrated with mass spectrometry and advanced bioinformatics tools, further increasing its usefulness in molecular analysis. The general result of all of this is faster and more comprehensive workflows in research.
Essentials for Improving Laboratory Techniques
Electrophoresis remains a fundamental technique across almost all lab disciplines. It may have simple principles, but sometimes simple is just what you need (especially in an area as complex as science). Its impacts on genetics, diagnostics, quality control, and forensics are undeniable.
When you understand all the ways this technique can be used, you can achieve accurate results and continue to innovate in your own research endeavors. For more information, you can always contact us at BaneBio. We’re happy to talk science and provide you with the equipment you need!